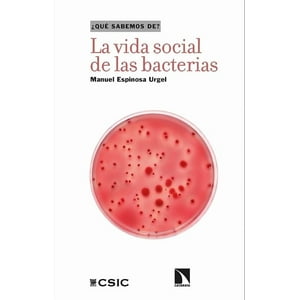
Océano - Libro La Vida Social De Las Bacterias - Un Viaje Al Mundo D

Océano
Océano - Libro Las Siete Frecuencias De La Comunicación - Clotilde Leguil | Lider Electrohogar
Precio: $ 17.855
Visitar Lider Electrohogar
Prueba buscando otros productos en:
Historial de precios
Fecha
05 Dic
Precio
$ 17.855
Océano - Libro Las Siete Frecuencias De La Comunicación - Clotilde Leguil | Lider Electrohogar
$ 17.855
Visitar Lider Electrohogar
Características técnicas
Marca
Océano
Descripción
Presenta un modelo innovador de comunicación basado en siete frecuencias combina psicología, liderazgo y desarrollo personal cómo comunicas, define cómo te conectas. ¿eres un… motivador, retador, comandante, sanador, profesor, visionario, maven? descubre las frecuencias ocultas de la conexión humana. erwin raphael mcmanus, reconocido orador y autor mundial, ha dedicado más de 45 años a estudiar el comportamiento humano y la comunicación. sus ideas han impactado a millones en más de 100 países. a partir de su profunda experiencia, mcmanus ha destilado la comunicación en un sistema de siete frecuencias únicas. cada una de ellas como una herramienta poderosa para conectar auténticamente. comprender estas frecuencias puede transformar cómo te comunicas con todos en tu vida: tu audiencia, tus colegas, tu equipo, tu familia y tus seres queridos. ¿estás listo para descubrir y dominar tu frecuencia? conéctate como nunca antes.
Marca
Océano
Descripción
Presenta un modelo innovador de comunicación basado en siete frecuencias combina psicología, liderazgo y desarrollo personal cómo comunicas, define cómo te conectas. ¿eres un… motivador, retador, comandante, sanador, profesor, visionario, maven? descubre las frecuencias ocultas de la conexión humana. erwin raphael mcmanus, reconocido orador y autor mundial, ha dedicado más de 45 años a estudiar el comportamiento humano y la comunicación. sus ideas han impactado a millones en más de 100 países. a partir de su profunda experiencia, mcmanus ha destilado la comunicación en un sistema de siete frecuencias únicas. cada una de ellas como una herramienta poderosa para conectar auténticamente. comprender estas frecuencias puede transformar cómo te comunicas con todos en tu vida: tu audiencia, tus colegas, tu equipo, tu familia y tus seres queridos. ¿estás listo para descubrir y dominar tu frecuencia? conéctate como nunca antes.
Prueba buscando otros productos en:
Productos relacionados
Océano
Océano - Libro Las Preguntas De La Embarazada - Jessica Hagy
$ 23.054
Océano
Océano - Libro Por Encima De La Ciudad, Por Debajo De Las Estrellas
$ 32.610
$ 25.883
20%de descuento.
Océano
Océano - Libro Las Cenizas De Angela - Expres/Maeva - La Voz Que Se
$ 18.651
$ 15.440
17%de descuento.
Océano
Océano - Libro Las Pandemias - Una Revisión De Las Grandes Pandemias
$ 16.917
$ 14.816
12%de descuento.
Océano
Océano - Libro La Vida Social De Las Bacterias - Un Viaje Al Mundo D
$ 16.917
$ 14.816
12%de descuento.
Debolsillo
Debolsillo - Las Siete Hermanas (Estuche Con: Las Siete Hermanas | La Hermana Tormenta)
$ 19.290
$ 16.590
13%de descuento.
Océano
Océano - Libro El Pequeño Libro De Las Runas - Madeleine Du Frayne
$ 14.080
$ 12.405
11%de descuento.
Océano
Océano - Libro Las Singladuras Pendientes Entre America
$ 24.530
$ 20.437
16%de descuento.
Océano
Océano - Libro Las Claves Genéticas-Richard Rudd
$ 59.490
$ 48.731
18%de descuento.
Océano
Océano - Libro Las Huellas De Los Dioses - Graham Hancock
$ 46.160
$ 38.823
15%de descuento.
Océano
Océano - Libro Pequeño Libro De La Numerologí - Ignacia Glebe
$ 26.316
$ 21.956
16%de descuento.